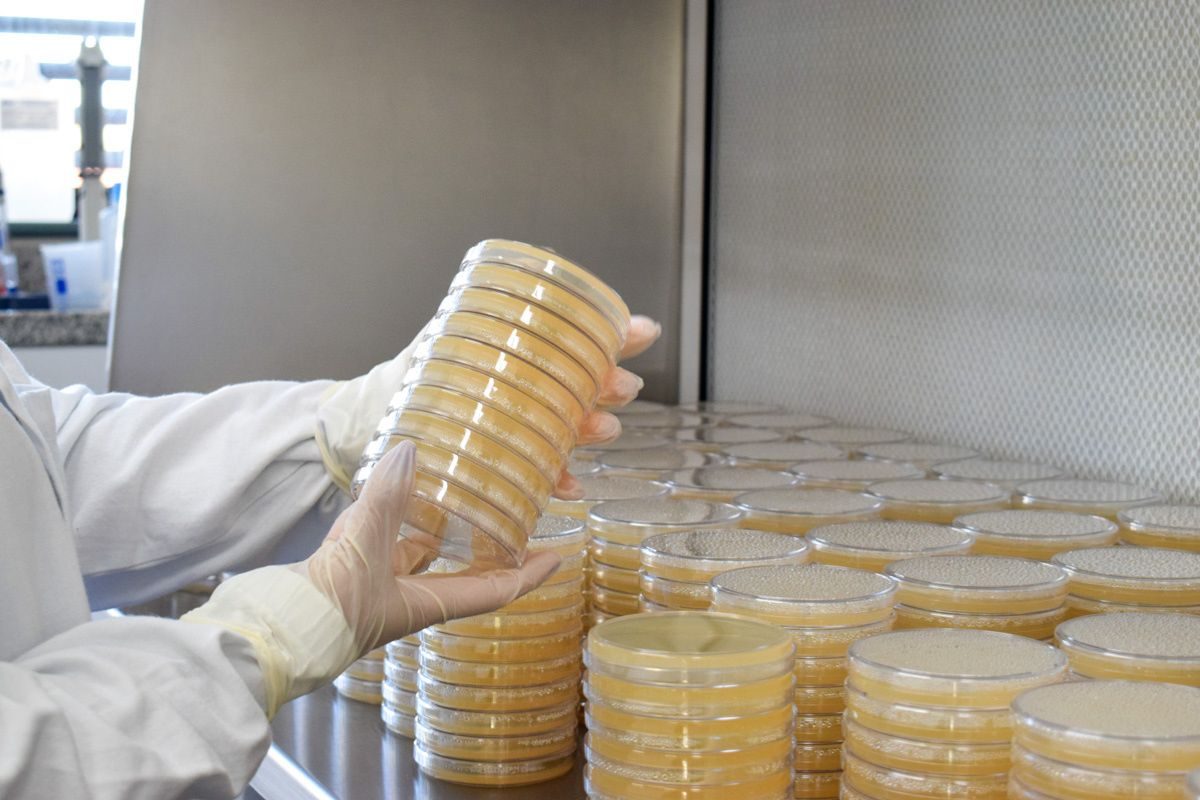

Com mais de 3 mil testes mensais, UPF lidera a testagem de sêmen suíno no Brasil, analisando 45% do material vendido no mercado nacional.
A proteína suína é uma das principais consumidas no Brasil. Segundo a Associação Brasileira dos Criadores de Suínos (ABCS), cada brasileiro consumiu cerca de 20,68 quilos de carne suína em 2023. A qualidade dessa proteína começa ainda na etapa de reprodução, incluindo a testagem do sêmen suíno, um processo crucial para garantir o sucesso da produção. Nesse contexto, o laboratório de sanidade da Universidade de Passo Fundo (UPF), no Rio Grande do Sul, destaca-se como o maior testador desse material genético no país.
“Por mês, são aproximadamente três mil análises”, explica ao Agro Estadão o gerente da Divisão de Prestação de Serviços da UPF, Clóvis Tadeu Alves. O laboratório testa cerca de 45% de todo o sêmen suíno comercializado no mercado nacional. Esse volume expressivo de análises foi viabilizado por uma parceria estratégica entre a UPF e a empresa Bretanha Suínos.
“Nós temos uma parceria. A empresa direciona toda a parte da qualidade do sêmen para o nosso laboratório”, afirma Alves. Ele acrescenta que todo o sêmen processado pela UPF é direcionado para grandes frigoríficos e produtores, o que reforça o papel do laboratório na cadeia produtiva da carne suína.
O processo de análise é rigoroso. As amostras de sêmen vêm de diferentes reprodutores de várias regiões do país. No laboratório, são avaliados aspectos como o formato do sêmen, características genéticas e a presença de contaminantes, como bactérias. Por exemplo, amostras com um percentual elevado de espermatozoides com cauda curta são descartadas, pois esse fator prejudica a fecundação. “Uma vez confirmada a qualidade, o lote de sêmen fica disponível para venda”, explica Alves.
Garantia de sucesso na reprodução
A testagem garante que o sêmen suíno utilizado na inseminação tem alta probabilidade de fecundação, além de ser livre de contaminações. “Para o produtor, é uma garantia de sucesso na reprodução”, destaca o gerente. Além disso, o processo assegura que o potencial genético de suínos superiores será preservado e transmitido aos leitões, garantindo, ao final da cadeia, uma carne de qualidade para o consumidor.
Com o objetivo de expandir seus serviços, a UPF planeja ampliar suas atividades laboratoriais para outros segmentos do agronegócio. “A nossa meta é criar um conglomerado de análises do Agro, um dos mais complexos do Sul do país”, revela Alves. A universidade já oferece análises em áreas como leite, alimentos, sanidade, solos e sementes, e busca aumentar sua participação nesses mercados.
Dados recentes do IBGE sobre o setor de suínos
De acordo com os últimos dados do IBGE, o rebanho de suínos no Brasil atingiu 44,2 milhões de cabeças em 2023, consolidando o país como um dos maiores produtores mundiais. A produção de carne suína também apresentou um crescimento, com 4,5 milhões de toneladas produzidas no mesmo ano. Esse cenário reflete a importância econômica do setor, que conta com tecnologias avançadas, como a testagem de sêmen, para garantir a qualidade e a produtividade da carne suína brasileira.
Compre Rural com informações do Agro Estadão
Quer ficar por dentro do agronegócio brasileiro e receber as principais notícias do setor em primeira mão? Para isso é só entrar em nosso grupo do WhatsApp (clique aqui) ou Telegram (clique aqui). Você também pode assinar nosso feed pelo Google Notícias. Lideranças da categoria participaram de reunião no Palácio do Planalto com o ministro Guilherme Boulos, da Secretaria-Geral da Presidência da República, e com Guilherme Theo Rodrigues da Rocha Sampaio, diretor-geral da Agência Nacional de Transportes Terrestres. Continue Reading Caminhoneiros reúnem-se com o governo federal e confirmam: não haverá paralisação Com foco em segurança jurídica, a nova legislação para o trabalho no campo busca modernizar normas vigentes desde 1973, simplificar contratos de safra e impulsionar a inovação tecnológica no agronegócio Continue Reading Nova legislação para o trabalho no campo avança após aprovação no Senado Empresa valoriza o ativo da pecuária e a performance animal no mundo do rodeio com premiação de R$ 100 mil para o chamado Touro do Ano da PBR e visa impulsionar a cultura agro no Brasil Continue Reading Connan fecha parceria com PBR e vai premiar o Touro do Ano Em 12 meses, o Índice Nacional de Preços ao Consumidor Amplo 15 (IPCA-15) acumula alta de 3,9%, dentro da meta do governo, que tolera até 4,5% ao ano. Continue Reading Prévia da inflação de março fica em 0,44%, pressionada por alimentos Agência de Defesa Agropecuária intercepta carga vinda do Amazonas; ausência de documentos obrigatórios e selos sanitários em polpa de açaí sem registro acende alerta para riscos de contaminação e falta de rastreabilidade na região. Continue Reading Operação apreende 2 mil litros de polpa de açaí sem registro em barcos Treinamento em Santa Catarina reuniu 11 países e mostrou, na prática, como produção e alimentação escolar se conectam na oferta de alimentos seguros. Caminhoneiros reúnem-se com o governo federal e confirmam: não haverá paralisação
Nova legislação para o trabalho no campo avança após aprovação no Senado
Connan fecha parceria com PBR e vai premiar o Touro do Ano
Prévia da inflação de março fica em 0,44%, pressionada por alimentos
Operação apreende 2 mil litros de polpa de açaí sem registro em barcos
Mapa apresenta experiência brasileira em segurança dos alimentos a países do Caribe e da América Central





